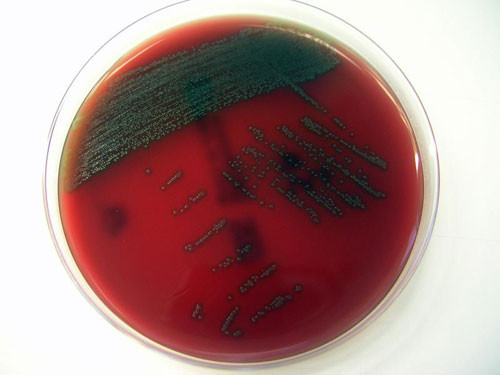

Các nhà khoa học đã xác định được một vi khuẩn phổ biến trong miệng có thể gây ra những bệnh nghiêm trọng nếu nó đi vào máu, theo trang tin Top News.
Vi khuẩn nói trên đã được các nhà nghiên cứu Đại học Zurich (Thụy Sĩ) đặt tên là Streptococcus Tigurinus. Sự tương tự của Streptococcus Tigurinus với các vi khuẩn liên quan khác có nghĩa là nó đã tồn tại nhưng chưa được xác định.
![]() |
| Vi khuẩn Streptococcus Tigurinus - Ảnh: IDW-online |
Theo chuyên gia Andrea Zbinden thuộc Viện Vi sinh vật y khoa Zurich và là trưởng nhóm nghiên cứu, việc xác định chính xác loại vi khuẩn này là điều hết sức cần thiết nhằm theo dõi sự lây lan của nó, từ đó có thể điều trị bệnh nhân nhiễm khuẩn một cách nhanh chóng và đúng thuốc.
Streptococcus Tigurinus được cô lập từ máu của bệnh nhân bị viêm nội tạng tâm mạc, viêm màng não và viêm cột sống.
Nó có sự tương đồng chặt chẽ với các chủng Streptococcus khác xâm chiếm miệng. Chảy máu nướu răng là một con đường tiềm tàng để vi khuẩn đường miệng xâm nhập vào máu.
“Vi khuẩn này dường như có tiềm năng gây ra bệnh nghiêm trọng một cách tự nhiên và do đó, điều quan trọng là các bác sĩ lâm sàng và các nhà vi sinh học ý thức được sự tồn tại của nó”, ông Zbinden kết luận.